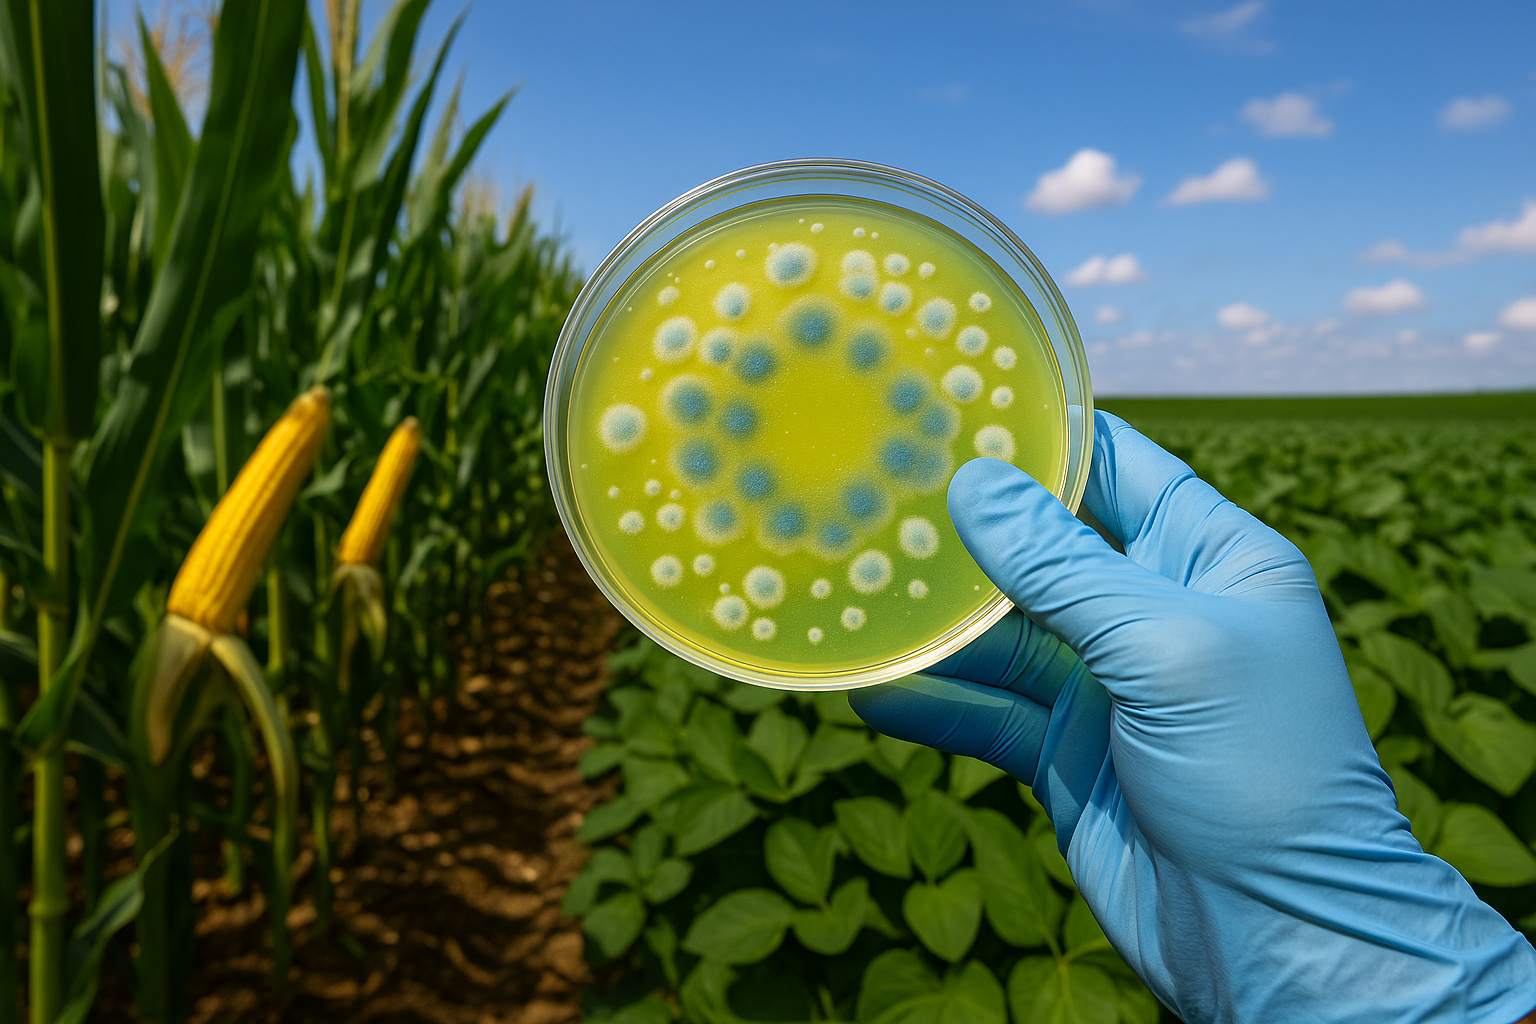
Placa de Petri com bactérias antifúngicas em lavoura de milho e soja

Novel Biological Product in Brazil Combats Fungi with High Efficacy
With the aim of transforming disease control in crops, Embrapa and the company Simbiose launched the effective biofungicide Eficaz Control.
The product is the first in Brazil to use the bacterium Paenibacillus ottowii as a biological control agent in plantations.
The solution achieves up to 80% efficiency in combating fungi such as Fusarium spp., Macrophomina phaseolina, and Colletotrichum graminicola.
-
India’s Sugar Export Cuts and Ethanol Shift Amid El Niño Threat Could Impact Global Prices and Stocks
-
Quarantine Pest Threatening Palm Trees Puts Brazilian Authorities on Alert, Prompts Monitoring at University of Taubaté and Potential Control Measures Across São Paulo
-
Global Alert: Report Finds 159 Pesticides in Coffee Beans Sold in Europe, Posing Serious Risks to Millions of Farm Workers
-
Low-Demand Brazilian Beef Offal Gains Popularity Abroad: Indonesia Purchases $19.5 Million, Boosting Revenue and Reducing Waste
These pathogens directly affect the roots and stalks of crops such as corn and soybeans.
In addition, the biofungicide also uses a strain of the bacterium Bacillus velezensis, equally promising in tests.
Researchers discovered the two strains in the Minas Gerais Cerrado, in the city of Sete Lagoas, during research initiated in 2016.
Embrapa Milho e Sorgo was responsible for conducting the studies, with support from the Microbiology and Phytopathology teams.
Official Launch Will Occur in August at The Andav Congress
The company will present Eficaz Control during the Andav Congress, which will take place from August 5 to 7, 2025.
The organization will hold the event at the Transamérica ExpoCenter in São Paulo and will bring together specialists from across the national agricultural sector.
National Technology Showed Superior Performance to Chemicals
According to Artur Soares, research director at Simbiose, field tests began in 2020 and covered several regions of Brazil.
The biofungicide outperformed chemical products in all scenarios, both in controlling diseases and in agricultural productivity.
Embrapa researcher Christiane Paiva states that development took more than nine years of studies and analyses.
The researchers evaluated 190 microbial samples and selected only two strains as effective in control and stimulation of plant growth.
The farmer applies the product directly to the seeds, which protects the plant from the beginning of development and reduces losses.
Innovation Strengthens The National Biological Inputs Industry
Marcelo de Godoy Oliveira, CEO of the Cogny ecosystem, highlights the potential of Eficaz Control to democratize the national agricultural market.
Today, five multinational companies concentrate more than half of the fungicide market aimed at soybeans.
The segment generates over R$ 400 million annually in chemical inputs.
Only 1.5 million of the 40 million hectares of soybeans in the country use biological inputs in their fields.
With the new biofungicide, Simbiose hopes to expand its operations and offer a competitive and national alternative to the market.
Eficaz Control allows use in various crops without requiring specific registration by crop, unlike chemical products.
Direct Application to Seeds Protects Crops from The Start
Researcher Rodrigo Véras explains that Eficaz Control is applied directly to seeds, focusing on early disease control in the soil.
This strategy reduces damage caused by fungi and improves the use of agricultural inputs.
Genetic resistance is still limited, and chemical control has low efficacy, especially for fungi that remain in the soil.
According to Véras, symptoms often only appear when the infestation is already advanced and losses are inevitable.
Moreover, crop rotation does not always work against the pathogens present in the roots and soil.
Partnership with The Private Sector Accelerates The Use of Bioinputs
Alexandre Ferreira da Silva, from Embrapa Milho e Sorgo, emphasizes that, for this reason, partnerships with the private sector significantly accelerate innovation in agriculture.
Moreover, bioinputs represent a sustainable advancement, as they offer lower environmental impact and, at the same time, greater efficiency in disease control in the fields.
Luciano Cota, another researcher from Embrapa, highlights that, by combining microorganisms with different modes of action, it is possible to prevent the emergence of resistance.
Thus, this mechanism ensures greater effectiveness over multiple harvests and, also, under different environmental conditions faced by producers.
Therefore, biological control proves to be more stable, reliable and, above all, advantageous over time in cultivation.
Multidisciplinary Team Contributed to The Development of Eficaz Control
More than 15 researchers from Embrapa Milho e Sorgo, therefore, directly participated in the development of Eficaz Control, evidencing the strength of the project.
Among those involved are Christiane Paiva, Rodrigo Véras, and Luciano Cota.
In addition, other relevant names from national research in microbiology and phytopathology are also participating.
Additionally, researchers from Embrapa Pesca e Aquicultura contributed, such as Rodrigo Munhoz, as well as master’s and doctoral scholars who supported the final stages.
During nine years of continuous research, the studies gradually advanced. Therefore, the ideal formula was developed and subsequently validated in several Brazilian regions.
As soon as the strains were selected, they were transferred to Simbiose through a technical cooperation agreement signed with Embrapa.
Finally, the company formulated the final product and, after the necessary procedures, registered it commercially under the name Eficaz Control.


 Portuguese
Portuguese  Spanish
Spanish